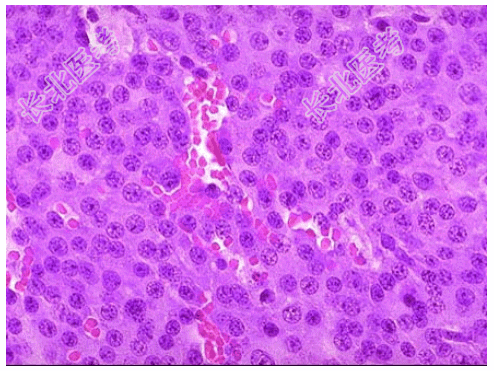

试题详情
- [材料题] 患者女性,32岁,停经、泌乳,泌乳素升高为主要临床表现就诊,入院后MRI示垂体腺形态异常。手术探查见蝶鞍区一境界清楚肿物,直径大约2cm,切除送检镜下如图,临床诊断为垂体腺瘤。
- 简答题1、该疾病好发于?
关注下方微信公众号,搜题查看答案

- 简答题2、该疾病病理学改变表现为?
关注下方微信公众号,搜题查看答案

- 简答题3、该疾病分子遗传学表现为?
关注下方微信公众号,搜题查看答案

- 简答题4、该疾病的预后如何?
关注下方微信公众号,搜题查看答案

热门试题
- 1、最可能的诊断是?2、该疾病的临床特征
- 1、该疾病的病因包括?2、该疾病细菌侵入
- 1、该疾病肉眼改变表现为?2、该疾病镜下
- 1、该疾病病因包括?2、该疾病肉眼改变表
- 1、最可能的诊断为?2、该肿瘤的性质为?
- 1、该疾病可有哪些镜下改变?2、该疾病可
- 1、该疾病免疫组化表达?2、该疾病需与哪
- 1、该疾病的病因和临床特点表现为?2、该
- 1、该疾病病因包括?2、该疾病多发于?3
- 1、该疾病多见于?2、该疾病肉眼改变表现
- 1、此病变应诊为?2、该疾病的临床特点是
- 1、患者肝组织活检的镜下观如下图所示,肝
- 1、该疾病病理学表现为?2、该疾病病免疫
- 1、该疾病病理特点表现为?2、该疾病的免
- 1、该疾病的免疫组化表现为?2、该疾病分
- 1、该疾病的病因和发病机制是?2、该疾病
- 1、套细胞淋巴瘤的分子遗传学特点性改变是
- 1、该疾病镜下改变表现为?2、该疾病免疫
- 1、该肿瘤最可能的病理诊断是?2、该疾病
- 1、该患者首先考虑?2、该疾病镜下改变表